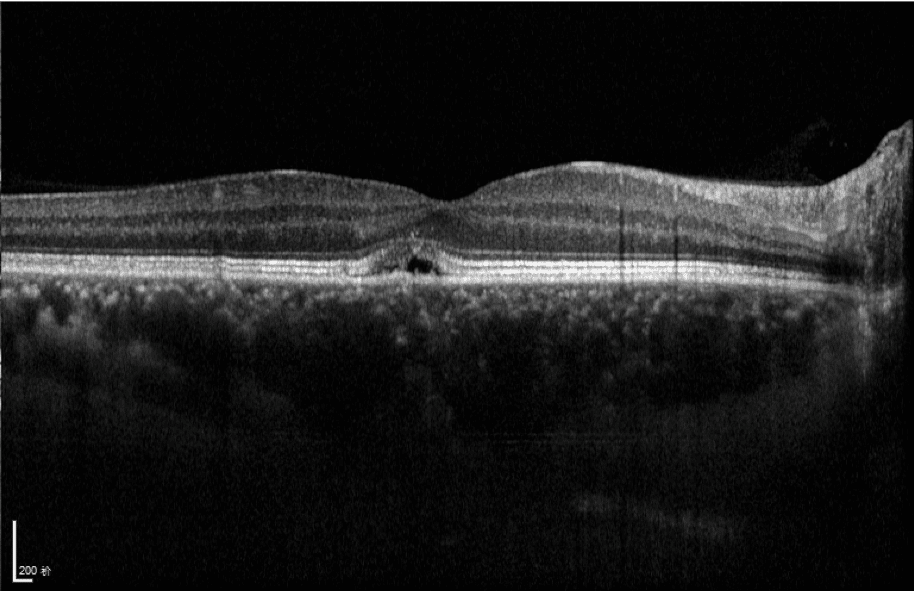

TOWARD PI®BMizar 400KHz Full-Range SS-OCT (BM-400Max)
400kHz speed full-range swept-source OCT for anterior and posterior
- 400,000 scans per second tdsafsadfdfo power your practice
- Full-Range wide-field Swept Source OCT
- Wide-field OCTA
- Choroid OCTA with Quantification Parameters
- HD Anterior Scan with Anterior OCTA